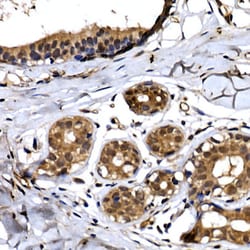
Invitrogen BTRC Polyclonal Antibody 100 &mu;L; Unconjugated:Antibodies,

Promotional price valid on web orders only. Your contract pricing may differ. Interested in signing up for a dedicated account number?
Learn More
Learn More
Invitrogen™ BTRC Polyclonal Antibody


Rabbit Polyclonal Antibody
Supplier: Invitrogen™ PA5109459
Description
Immunogen sequence: MDPAEAVLQE KALKFMCSMP RSLWLGCSSL ADSMPSLRCL YNPGTGALTA FQNSSEREDC NNGEPPRKII PEKNSLRQTY NSCARLCLNQ ETVCLASTAM.
This gene encodes a member of the F-box protein family which is characterized by an approximately 40 amino acid motif, the F-box. The F-box proteins constitute one of the four subunits of ubiquitin protein ligase complex called SCFs (SKP1-cullin-F-box), which function in phosphorylation-dependent ubiquitination. The F-box proteins are divided into 3 classes: Fbws containing WD-40 domains, Fbls containing leucine-rich repeats, and Fbxs containing either different protein-protein interaction modules or no recognizable motifs. The protein encoded by this gene belongs to the Fbws class; in addition to an F-box, this protein contains multiple WD-40 repeats. This protein is homologous to Xenopus bTrCP1, yeast Met30, Neurospora Scon2 and Drosophila Slimb proteins. It interacts with HIV-1 Vpu and connects CD4 to the proteolytic machinery. It also associates specifically with phosphorylated IkappaBalpha and beta-catenin destruction motifs, probably functioning in multiple transcriptional programs by activating the NF-kappaB pathway and inhibiting the beta-catenin pathway.
Specifications
| BTRC | |
| Polyclonal | |
| Unconjugated | |
| BTRC | |
| beta-transducin repeat containing E3 ubiquitin protein ligase; beta-transducin repeat containing protein; Beta-transducin repeat-containing protein; betaTrCP; Beta-TrCP; Beta-TrCP protein E3RS-IkappaB; Beta-Trcp1; Btrc; BTRCP; b-TrCP; bTrCP1; E3RSIkappaB; E3RS-IkappaB; epididymis tissue protein Li 2a; F-box and WD repeats protein beta-TrCP; F-box and WD-repeat protein 1B; F-box/WD repeat-containing protein 1A; Fbw1; FBW1A; FBXW1; FBXW1A; FWD1; HOS; Kiaa4123; LOW QUALITY PROTEIN: F-box/WD repeat-containing protein 1A; mE3RS-IkappaB; pIkappaBalpha-E3 receptor subunit; pIkappaB-E3 receptor subunit; SCF b-TRCP; Slimb; Ubiquitin ligase FWD1 | |
| Rabbit | |
| Affinity Chromatography | |
| RUO | |
| 12234, 361765, 8945 | |
| -20°C, Avoid Freeze/Thaw Cycles | |
| Liquid |
| ELISA, Immunohistochemistry (Paraffin), Western Blot, Immunocytochemistry | |
| 0.84 mg/mL | |
| PBS with 50% glycerol and 0.05% ProClin 300; pH 7.3 | |
| Q3ULA2, Q9Y297 | |
| BTRC | |
| Recombinant fusion protein containing a sequence corresponding to amino acids 1-100 of human β-TrCP/BTRC (NP_3786631). | |
| 100 μL | |
| Primary | |
| Human, Mouse, Rat | |
| Antibody | |
| IgG |
Product Content Correction
Your input is important to us. Please complete this form to provide feedback related to the content on this product.
Product Title
Spot an opportunity for improvement?Share a Content Correction